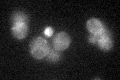
YER170W
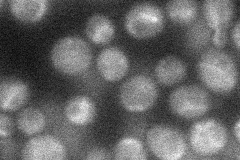
YER170W
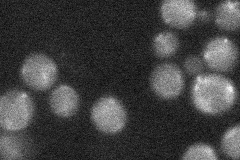
YER170W
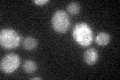
YER170W

View description
Mitochondrial adenylate kinase, catalyzes the reversible synthesis of GTP and AMP from GDP and ADP; may serve as a back-up for synthesizing GTP or ADP depending on metabolic conditions; 3' sequence of ADK2 varies with strain background
Localization:
Intensity:
Fold change:
Significance:
-
C’ GFP library in SD
mitochondria17.34 -
N' NOP1pr-GFP in SD
ambiguous,cytosol27.2727 -
N' TEF2pr-mCherry in SD

below threshold8.00537 -
N' NATIVEpr-GFP in SD
below threshold21.5498 -
N' TEF2pr-VC and Cyto-VN in SD

below threshold22.7596 -
C’ GFP library in SD+DTT
mitochondria16.40.94No -
C’ GFP library in SD+H2O2

mitochondria17.260.99No -
C’ GFP library in Starvation Media

mitochondria17.751.02No -
C’ GFP library on the background of Pup2-DaMP

mitochondria -
C’ GFP library on the background of CCT mutant

mitochondria15.6320.901235No
